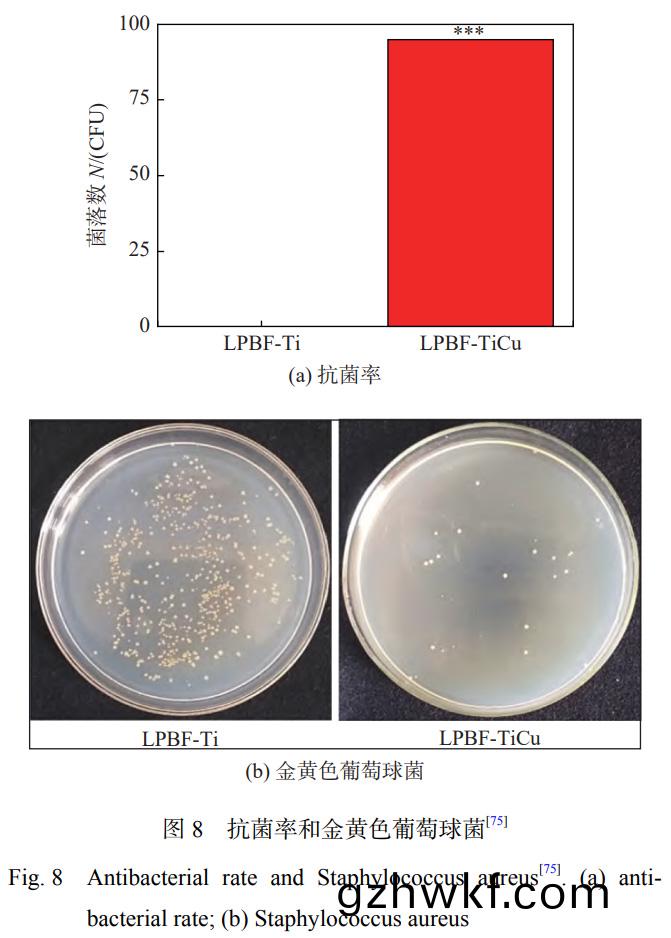
8.jpg

前言(yan)骨(gu)在人体内(nei)部(bu)主(zhu)要(yao)起(qi)到(dao)支撑作用,是一(yi)种具有愈合和再(zai)生(sheng)能(neng)力的硬(ying)组(zu)织[1]。由于(yu)骨的密(mi)度(du)大、硬度高、破(po)损后很(hen)难自(zi)然修复等特(te)殊(shu)性,必须进行(xing)骨(gu)移植(zhi)。钛合金(jin)因具有轻(qing)质(zhi)、弹(dan)性(xing)模(mo)量与(yu)人(ren)骨相(xiang)近(jin)、耐(nai)腐蚀(shi)、生物相(xiang)容(rong)性好等(deng)优(you)点[2−3],被广(guang)泛应(ying)用(yong)于工程机(ji)械(xie)、航(hang)空(kong)航(hang)天和(he)生物(wu)医学领(ling)域[4]。但(dan)是(shi)TC4基体对(dui)于(yu)金(jin)黄(huang)色(se)葡萄球(qiu)菌的(de)抗(kang)菌率(lv)仅(jin)为(wei)14.5%[5],且钛(tai)及钛合(he)金(jin)具(ju)有生物惰性(xing),与骨骼(ge)机械结(jie)合(he)的方式(shi)会(hui)导致摩擦产(chan)生(sheng)碎屑,最(zui)终(zhong)引发(fa)炎(yan)症,从而导(dao)致(zhi)植(zhi)入手术失败[6]。相(xiang)对于在提高(gao)钛(tai)合(he)金种(zhong)植体材(cai)料的(de)骨(gu)结(jie)合(he)、耐磨(mo)性(xing)和(he)耐蚀性(xing)方面的研(yan)究,针(zhen)对(dui)钛合金(jin)骨(gu)科(ke)植(zhi)入(ru)体细菌(jun)感染(ran)的研(yan)究仍处于早(zao)期(qi)阶段(duan)[7]。
植入手(shou)术术(shu)后感染是(shi)植入失败的(de)主(zhu)要原因之(zhi)一,细菌引(yin)起的(de)相关植入(ru)物(wu)感(gan)染(ran)风险从0.4%到(dao)16.1%不(bu)等[8]。引起细(xi)菌感(gan)染的(de)重(zhong)要(yao)原(yuan)因是生物(wu)膜的形(xing)成[9]及由粘附(fu)的微(wei)生物聚(ju)集产(chan)生致密(mi)的(de)胞外聚(ju)合(he)物(wu)[10]。因(yin)此(ci),防(fang)止(zhi)或降(jiang)低(di)生(sheng)物膜在(zai)植入过程(cheng)中的(de)形(xing)成具(ju)有(you)重要作(zuo)用(yong)。
目前,对(dui)于(yu)提高(gao)钛(tai)及(ji)钛(tai)合(he)金植入材(cai)料抗(kang)菌性能(neng)的(de)表面(mian)改性(xing)途径包括涂(tu)覆抗生(sheng)素、制备有(you)机抗(kang)菌(jun)剂(ji)和(he)无机抗菌剂(ji)涂(tu)层等(deng)技(ji)术(shu)来(lai)达(da)到灭(mie)菌(jun)的(de)作用(yong)[11]。研(yan)究(jiu)发现,钛(tai)合金(jin)表(biao)面(mian)制(zhi)备依诺沙星(xing)涂(tu)层(ceng)[12]、庆大霉(mei)素-HA涂(tu)层[13]、膦(lin)酸(suan)盐/季(ji)铵(an)盐共(gong)聚物(wu)涂层[14]等有机(ji)抗菌(jun)剂(ji)涂层对钛合(he)金(jin)的(de)抗菌(jun)性(xing)能都有较大程(cheng)度的提(ti)高。但是(shi),抗生素(su)、有机抗菌剂(ji)的大(da)量(liang)使用(yong)会导(dao)致(zhi)细菌产生耐药(yao)性(xing)且药物作用(yong)时(shi)间较短[15]。无机(ji)抗菌(jun)剂(ji)主(zhu)要包括(kuo)Ag+,Cu2+,Zn2+,Co2+等(deng),能(neng)够在(zai)人(ren)体(ti)内(nei)稳定发(fa)挥(hui)作(zuo)用且(qie)具(ju)有(you)优良的(de)抗菌性(xing)能和(he)生(sheng)物(wu)相(xiang)容(rong)性(xing)。目前(qian),在钛(tai)合金(jin)中添(tian)加无机(ji)抗菌(jun)金(jin)属(shu)元素(su)的(de)技(ji)术(shu)主要(yao)包括电(dian)弧(hu)熔炼(lian)、真空等(deng)离(li)子烧结、离(li)子(zi)注入(ru)、气(qi)相(xiang)沉积和(he)激(ji)光(guang)表(biao)面改(gai)性技(ji)术等,将(jiang)无机(ji)抗(kang)菌(jun)剂掺入(ru)合金体(ti)系或者(zhe)表面(mian),使植入(ru)材料(liao)获(huo)得抗(kang)菌(jun)性能。其(qi)中(zhong),激光表面改性技(ji)术具(ju)有(you)独特的技(ji)术(shu)优势,相(xiang)对(dui)于电(dian)沉(chen)积、PVD/CVD技术(shu),与基(ji)体材料(liao)具有(you)较(jiao)强(qiang)的(de)结合(he)力。相对(dui)于(yu)热喷(pen)涂(tu)技(ji)术(shu),具(ju)有较(jiao)小(xiao)的热(re)影(ying)响区[16],对基材(cai)的(de)影(ying)响较小(xiao)。因此,激(ji)光(guang)表面改(gai)性技(ji)术(shu)具(ju)有(you)广(guang)阔(kuo)的应用潜(qian)力。
激(ji)光表面(mian)改性(xing)技术(shu)既(ji)可(ke)以通过高(gao)温热(re)源(yuan)对表(biao)面进行重熔(rong)引发合(he)金相(xiang)转变或(huo)构(gou)建(jian)表(biao)面纹(wen)理(li)化来(lai)提高(gao)表面性(xing)能(neng),又(you)可(ke)以结合(he)外(wai)源物(wu)质(zhi)制(zhi)备具(ju)有(you)不(bu)同性能的表面(mian)涂层[17]。激光作(zuo)为(wei)一(yi)种(zhong)新(xin)型能源,具(ju)有局(ju)部选(xuan)择性、能(neng)量(liang)密(mi)度高、节省材(cai)料(liao)、凝固(gu)快、稀释率(lv)低、热(re)影响(xiang)区(qu)窄、冶(ye)金结合(he)强(qiang)度(du)高等优点(dian)[18],也可(ke)以对合(he)金(jin)的组织形(xing)态(tai)和析出(chu)相(xiang)进行调控(kong)[19],被广(guang)泛应用(yong)于材(cai)料加(jia)工领域(yu)。激光表面(mian)改(gai)性(xing)技术作为一(yi)种无机抗菌剂植(zhi)入技(ji)术(shu),在表面(mian)工程中(zhong)具有(you)广(guang)泛(fan)的应(ying)用(yong)前景。
钛及钛合(he)金作(zuo)为主要(yao)的(de)骨(gu)科(ke)植(zhi)入(ru)材(cai)料(liao),其抗(kang)菌(jun)性(xing)的研究成为(wei)重(zhong)中之(zhi)重(zhong),如何(he)利用激光(guang)表面(mian)改性(xing)技(ji)术(shu),改(gai)善(shan)植入物的抗(kang)菌(jun)性能成(cheng)为现阶(jie)段的研究(jiu)热点(dian)。文中(zhong)综述(shu)了激光(guang)表面(mian)改性(xing)技术(shu)的分(fen)类,以(yi)及采(cai)用激光表面(mian)改(gai)性(xing)技术对(dui)钛及(ji)钛合(he)金(jin)进(jin)行(xing)表(biao)面合金化、表(biao)面(mian)织(zhi)构和激光熔(rong)覆处(chu)理(li),研究(jiu)激光(guang)表面改性方式(shi)对钛(tai)合(he)金抗菌性能的(de)影(ying)响(xiang)并(bing)对(dui)抗(kang)菌(jun)机(ji)理(li)进(jin)行(xing)解释。
1、激(ji)光表面改(gai)性技术
激光(guang)表面改(gai)性技术利用激(ji)光(guang)热源与(yu)金(jin)属或非金(jin)属(shu)进(jin)行相互(hu)作(zuo)用(yong),通(tong)过(guo)添加(jia)相(xiang)同(tong)或不(bu)同(tong)材料(liao)或对(dui)材(cai)料(liao)表(biao)面(mian)进(jin)行重熔(rong)来(lai)改善基体的表面性(xing)能(neng),是一种(zhong)清洁、安(an)全、高(gao)效率(lv)的加(jia)工(gong)技术(shu)[20],是(shi)光(guang)学、冶金学、电子(zi)学(xue)、计算(suan)机(ji)学等(deng)为一体的(de)高(gao)新(xin)技术(shu),在现(xian)阶段(duan)具(ju)有广(guang)阔(kuo)的应(ying)用(yong)前景(jing)。
激(ji)光(guang)表面改(gai)性技(ji)术主要包括(kuo)表面(mian)硬(ying)化、激(ji)光(guang)重熔(rong)、织构(gou)化和激光(guang)熔覆等,分类(lei)如图1所(suo)示。

激光表(biao)面(mian)处(chu)理(li)技术(shu)在(zai)保护(hu)气(qi)氛(fen)或者(zhe)无保(bao)护(hu)气(qi)条(tiao)件下(xia)对材料进行表(biao)面加热(re)或重熔,可(ke)以对材(cai)料(liao)表面(mian)进(jin)行定(ding)向(xiang)处(chu)理(li),其(qi)原(yuan)理如(ru)图(tu)2所示。激(ji)光(guang)表(biao)面处(chu)理(li)包括(kuo)激光(guang)重熔、激光合金(jin)化(hua)、激(ji)光纹理(li)化和激(ji)光微(wei)纳加(jia)工(gong)等技术(shu)。固(gu)体材料在(zai)受(shou)到激光束的(de)作用下(xia),有(you)助于通过诱(you)导(dao)微(wei)观结构变化(hua)来(lai)进一步提(ti)高(gao)抗菌(jun)性(xing)能(neng)、表面硬(ying)度、耐(nai)磨(mo)性(xing)、耐(nai)腐蚀性(xing)等性(xing)能(neng),从(cong)而(er)实现(xian)表面改性(xing)[23]。同(tong)时,激(ji)光表面(mian)处(chu)理可应用(yong)于(yu)制(zhi)备微(wei)纳加(jia)工结(jie)构(gou)、改(gai)善金属表(biao)面性(xing)能和加强(qiang)固(gu)体(ti)材(cai)料(liao)粘(zhan)结强度等方面(mian)。

激(ji)光(guang)熔(rong)覆技术是(shi)利用激光(guang)束(shu)的高能量密度(du),将(jiang)基体(ti)材料熔化(hua)形(xing)成熔(rong)池(chi),由保护(hu)气体(ti)携(xie)带(dai)金属粉末(mo)或(huo)丝材(cai)同(tong)时注(zhu)入熔(rong)池(chi),从而将(jiang)其(qi)熔(rong)覆(fu)在受(shou)热(re)区域(yu)表(biao)面,形成具(ju)有冶金(jin)结合的(de)功(gong)能性涂(tu)层(ceng),提(ti)高材(cai)料(liao)的(de)表(biao)面(mian)性能(neng),其(qi)原理(li)如图3[24]所示。激光熔覆(fu)技术(shu)是上世(shi)纪90年(nian)代以(yi)来快速(su)发(fa)展的表面(mian)改(gai)性技(ji)术(shu),现阶段已(yi)经(jing)得到广泛(fan)应(ying)用(yong)[18]。激(ji)光(guang)熔覆(fu)技术具(ju)有热输入(ru)能量集(ji)中、热(re)影响(xiang)区(qu)小、变形(xing)小(xiao)、基(ji)体(ti)能(neng)够(gou)与(yu)熔覆(fu)层(ceng)形成(cheng)冶金(jin)结(jie)合(he)、熔覆层(ceng)稀(xi)释率(lv)低等优点[25−26]。激光(guang)熔覆技(ji)术主(zhu)要应用于(yu)提(ti)高基(ji)体(ti)耐(nai)磨(mo)性、耐蚀性(xing)、抗菌性和耐高(gao)温(wen)性能(neng)等(deng)[27]。

2、激光表面处理钛(tai)合金抗(kang)菌涂(tu)层(ceng)
激(ji)光本(ben)质(zhi)上是(shi)电(dian)磁(ci)波的(de)一种(zhong),按(an)照波长可分为(wei)紫(zi)外光(guang)、可(ke)见光(guang)和红(hong)外光[28]。根(gen)据(ju)激光器(qi)功率(lv)的(de)不同,选(xuan)择(ze)不同(tong)波长的激光对(dui)钛及(ji)钛合金进(jin)行处(chu)理(li)。现阶段,波(bo)长(zhang)小于(yu)355nm的短(duan)波(bo)长激(ji)光可以对钛及(ji)钛(tai)合金进(jin)行切(qie)割(ge);波(bo)长(zhang)为(wei)532nm的(de)绿(lv)光激(ji)光(guang)多(duo)用在(zai)医(yi)疗(liao)领(ling)域(yu)对钛及钛合金激(ji)光(guang)加工(gong)处理。激光表(biao)面(mian)处(chu)理技术主要(yao)通过改变(bian)钛合(he)金(jin)的(de)表(biao)面化学成(cheng)分和(he)表面(mian)结(jie)构,对(dui)钛(tai)合(he)金(jin)植入物(wu)的(de)抗菌(jun)性(xing)能(neng)进行(xing)调控。
在(zai)激(ji)光(guang)表(biao)面(mian)处理过程(cheng)中,由于合金元(yuan)素(su)、表面结(jie)构和熔覆(fu)体系的(de)不同,对激(ji)光表(biao)面处(chu)理(li)钛及(ji)钛(tai)合金的结构(gou)和性能(neng)有(you)不(bu)同程(cheng)度(du)的影(ying)响,从(cong)而(er)达到(dao)不同(tong)的(de)抗(kang)菌效(xiao)果。
2.1 激光(guang)表面合(he)金化
激(ji)光(guang)表(biao)面(mian)合(he)金化技(ji)术(shu)(LSA)是利(li)用激光热(re)源(yuan)将(jiang)基材熔(rong)化形(xing)成(cheng)熔(rong)池(chi),将高(gao)性能合金(jin)粉(fen)或(huo)气体(ti)与基(ji)体发(fa)生反(fan)应(ying)形(xing)成一层新(xin)的(de)合金(jin)化(hua)层(ceng),从(cong)而使材料(liao)具有高性能(neng)[29]。
通过(guo)激光(guang)表面(mian)合(he)金(jin)化(hua)技术在合金表(biao)面(mian)添(tian)加(jia)适(shi)当含量(liang)的(de)抗菌元素(su),可(ke)改(gai)变材料(liao)表面的合(he)金成分(fen)。同(tong)时(shi),由于(yu)激光能量(liang)可(ke)以(yi)熔(rong)化涂层(ceng)和(he)部分底层基(ji)体,激(ji)光(guang)表面合金化技术(shu)可(ke)以(yi)在合金(jin)层(ceng)和基(ji)体之(zhi)间形成牢(lao)固的冶(ye)金结合(he)。QIAO等学者[30]使用波长(zhang)较(jiao)短(0.9μm)的高功率(lv)二(er)极管(guan)激光(guang)器(qi)制(zhi)备了(le)TiNi与Ag的激(ji)光(guang)合金化涂层。研(yan)究(jiu)表(biao)明:通(tong)过合(he)金化(hua)技(ji)术(shu)可(ke)以(yi)使涂(tu)层中(zhong)含有(you)更(geng)多的(de)Ti2Ni,β-Ti和Ag颗(ke)粒;在银(yin)含(han)量(质(zhi)量(liang)分数)为4.6%时,涂层(ceng)的硬度(du)提高(gao)了109%;同时(shi),合(he)金(jin)化后涂层(ceng)释放的Ag+和(he)Ag颗粒显(xian)著提(ti)高(gao)了(le)对(dui)大肠杆(gan)菌(jun)和金黄(huang)色(se)葡(pu)萄球(qiu)菌的抗菌(jun)效果(guo)。
在(zai)激光(guang)处(chu)理(li)过程中(zhong),保护(hu)气(qi)体不(bu)仅可(ke)以(yi)降(jiang)低空(kong)气(qi)中氧气和水(shui)分等对(dui)激光(guang)表(biao)面(mian)处(chu)理(li)的干(gan)扰(rao)和(he)污(wu)染,提高(gao)表(biao)面(mian)处理(li)的质量和(he)效(xiao)率(lv)[31],还(hai)可(ke)以(yi)与基(ji)体(ti)发生反应,形(xing)成合(he)金(jin)化(hua)涂(tu)层。由于氮和(he)钛(tai)在(zai)热(re)力(li)学上(shang)存(cun)在有(you)利的(de)相互(hu)作(zuo)用,形(xing)成(cheng)的氮化层(ceng)对(dui)钛合金的硬(ying)度(du)和摩擦学(xue)性能有很大的提高(gao)[32]。钛的(de)氮(dan)化(hua)物(wu)(TiN)、氧化(hua)物(wu)(TiO2)等[31]都具(ju)有(you)本征(zheng)抗菌性能。邹洁(jie)等(deng)学者(zhe)[33]在牙(ya)科钴(gu)铬(ge)合金表(biao)面制备(bei)一层(ceng)2.5μm厚(hou)度(du)的TiN涂层,之后(hou)对(dui)涂层(ceng)进(jin)行耐腐蚀(shi)和(he)抗菌性(xing)试(shi)验(yan),发(fa)现:TiN涂层(ceng)对变形(xing)链球(qiu)菌或黏性(xing)放线(xian)菌有(you)很好的抗菌性能(neng)。
DONAGHY等学(xue)者[34]利用(yong)光纤激光技术在高纯(chun)N2保(bao)护(hu)下(xia)对TNZT(Ti-35Nb-7Zr-6Ta)合金进(jin)行(xing)处理,研究(jiu)激光(guang)氮(dan)化(hua)处理对合金(jin)表面(mian)形(xing)貌、粗(cu)糙(cao)度(du)、润湿角以(yi)及抗(kang)菌(jun)性(xing)能(neng)的(de)影响。结(jie)果(guo)表(biao)明:激光(guang)氮化(hua)处理后(hou)XRD检测(ce)到较(jiao)强的(de)TiN峰值强(qiang)度(du),能够(gou)显著(zhu)提(ti)高(gao)表(biao)面粗(cu)糙(cao)度(du)至1180.2nm,润(run)湿角降(jiang)低(di)至27.1°,亲水性(xing)和生物相(xiang)容性(xing)进一(yi)步提(ti)高,其(qi)抗菌(jun)效(xiao)果(guo)如图(tu)4[34]所(suo)示,合金表(biao)面(mian)细菌(jun)覆(fu)盖率(lv)降(jiang)低(di)至0.72%。

钛及(ji)钛(tai)合金相对(dui)于(yu)其(qi)他材(cai)料抗(kang)菌和(he)耐腐(fu)蚀(shi)的(de)主(zhu)要优(you)点是(shi)可(ke)以(yi)在表面生(sheng)成一层(ceng)TiO2陶(tao)瓷膜(mo)[35]。研(yan)究表(biao)明:钛合(he)金(jin)在正常(chang)温(wen)度下(xia)暴(bao)露1年,所(suo)形(xing)成(cheng)的(de)TiO2氧化(hua)膜(mo)的(de)厚(hou)度为6nm,且与基体(ti)结合性很(hen)差(cha),在较(jiao)低的(de)剪(jian)切(qie)力(li)作用下就会(hui)被破(po)坏[7]。激光(guang)表面处理可(ke)以改变氧(yang)化膜的(de)厚度和表面(mian)粗(cu)糙度,进(jin)而(er)提高(gao)合(he)金(jin)的(de)性(xing)能。
FATHI-HAFSHEJANI等(deng)学(xue)者(zhe)[36]在(zai)氧气(qi)氛围内(nei)对钛合(he)金进行激光表面改(gai)性处(chu)理(li),钛合(he)金基(ji)体(ti)表(biao)面形成(cheng)物(wu)相和(he)形貌可(ke)控的(de)高(gao)纯度TiO2涂层。由(you)于晶(jing)体TiO2涂(tu)层产生(sheng)的光催化(hua)活(huo)性,具有不同(tong)相(xiang)(锐(rui)钛矿(kuang)、金红石(shi))和(he)不(bu)同(tong)形态(tai)的(de)TiO2涂(tu)层(ceng)在增强(qiang)骨整(zheng)合(he)和抗(kang)菌行为方(fang)面表现(xian)出(chu)优(you)异(yi)的(de)性能(neng)。PARMAR等(deng)学者(zhe)[37]通(tong)过(guo)对TC4进行纳秒(miao)激光和(he)氧(yang)化(hua)处(chu)理(li)。研究表(biao)明(ming):纳秒激光(guang)处(chu)理表面(mian)发生(sheng)微坑形式(shi)的(de)物理和(he)化学(xue)变化(hua),表(biao)面(mian)电荷(he)发生(sheng)变化(hua),Ti的氧化(hua)物(wu)含量增加,氧化可(ke)以(yi)促(cu)进(jin)激光微(wei)织(zhi)构(gou)对(dui)金(jin)黄(huang)色(se)葡萄球菌(jun)的粘附和(he)增(zeng)殖能力的(de)抑制。
钛(tai)与空(kong)气(qi)中(zhong)的(de)碳、氢等都有非常高(gao)的(de)反应活性(xing)。CUNHA等(deng)学(xue)者(zhe)[38]在空(kong)气(qi)中(zhong)对钛(tai)进(jin)行激(ji)光(guang)表面(mian)处理(li),在(zai)进行(xing)XPS检测时,发(fa)现其(qi)有(you)较高(gao)的(de)碳(tan)峰,原因是空气(qi)中含有(you)较多(duo)的含碳污(wu)染物(wu)[39]。氩气作(zuo)为一种常(chang)见(jian)的惰(duo)性(xing)保(bao)护(hu)气体(ti),其(qi)多(duo)用(yong)于激(ji)光(guang)焊接(jie)和激光熔(rong)覆过程(cheng)中防止(zhi)有(you)益元(yuan)素的烧(shao)损(sun)和(he)合金化(hua)[40],在钛(tai)及(ji)钛(tai)合(he)金(jin)表面激光处理(li)用(yong)以(yi)提(ti)高(gao)抗(kang)菌(jun)性能中的(de)应用(yong)较(jiao)少。
2.2 激光表面织构
激(ji)光(guang)表面(mian)织构技(ji)术(shu)可以(yi)对(dui)钛合金进(jin)行表面结(jie)构设计(ji)或(huo)者(zhe)进(jin)行重(zhong)熔处(chu)理(li),改善(shan)钛(tai)及(ji)钛合金的表面(mian)结(jie)构(gou)。现(xian)阶(jie)段,通(tong)过(guo)激(ji)光表面织构(gou)技术可以(yi)在(zai)钛(tai)及钛合(he)金(jin)表(biao)面(mian)制备(bei)微(wei)米(mi)和纳米(mi)尺(chi)寸的结(jie)构或纹理结(jie)构(gou),进而影响合(he)金表(biao)面(mian)的(de)氧化(hua)膜(mo)厚(hou)度和表(biao)面粗糙(cao)度,降低(di)表面载流子(zi)数量、提(ti)高(gao)表面(mian)峰度(du),有效(xiao)地(di)减(jian)少(shao)细(xi)菌的黏(nian)附或灭活(huo)细菌[41]。
纳米(mi)级表面特(te)征有利(li)于减(jian)少(shao)细(xi)菌黏(nian)附和生(sheng)长。CHAN等学者(zhe)[7]通(tong)过(guo)连续(xu)波光(guang)纤(xian)激(ji)光(guang)器(qi)发射波(bo)长(zhang)为(wei)1064nm近(jin)红外(wai)激(ji)光(guang)对(dui)商业纯钛(cp-Ti)和(he)TC4进(jin)行激(ji)光(guang)表面(mian)处(chu)理(li)诱导纳米特征(zheng)结(jie)构(gou)的产(chan)生,其(qi)处(chu)理(li)后(hou)表面如图5所示(shi)。激(ji)光(guang)处(chu)理(li)表(biao)面(mian)由波纹(wen)和(he)放射(she)状(zhuang)片层(ceng)构(gou)成(cheng)的(de)玫(mei)瑰状标(biao)记(ji)组成(cheng),2种(zhong)钛(tai)合(he)金均(jun)表(biao)现(xian)出较(jiao)强的抗(kang)菌性(xing)能。从表(biao)面疏(shu)水性(xing)、膜(mo)成(cheng)分、厚度(du)和(he)粗(cu)糙(cao)度(du)等方面对(dui)抗(kang)菌机理进行解(jie)释(shi):①研(yan)究发(fa)现(xian),金黄色葡(pu)萄(tao)球(qiu)菌是疏(shu)水性的(de),其水接(jie)触角(jiao)为(wei)72.2°[42],而(er)经(jing)过(guo)激光(guang)处理(li)的表面(mian)表(biao)现出(chu)更强(qiang)的(de)亲水性,水(shui)接(jie)触角降低到(dao)30°~45°,减少(shao)了(le)细(xi)菌的接(jie)触。②细菌(jun)与(yu)植(zhi)入(ru)物表(biao)面接(jie)触是在表面(mian)电(dian)荷与(yu)细菌(jun)的(de)静电(dian)相(xiang)互(hu)作(zuo)用下进(jin)行(xing)吸引,使(shi)细菌(jun)黏附(fu)在(zai)植入物表面,在(zai)氮(dan)气(qi)环境(jing)中(zhong)进(jin)行激(ji)光(guang)表面(mian)处(chu)理(li)会增大(da)表(biao)面(mian)膜层(ceng)的厚(hou)度(du),减少表(biao)面载流(liu)子(zi)的(de)数(shu)量[43]。同(tong)时,表面(mian)膜层(ceng)中存在(zai)大量(liang)的(de)缺陷和(he)空位(wei),会(hui)造成电荷的富集,减(jian)少(shao)与(yu)细(xi)菌的相(xiang)互作(zuo)用[7]。③激光表面织(zhi)构会增(zeng)加(jia)材料的表面粗糙(cao)度(du),相(xiang)同的表(biao)面粗(cu)糙(cao)度具有不同的(de)峰度(du)(Rku)和(he)偏(pian)度(Rsk)[44],激光(guang)处(chu)理的(de)钛(tai)合金表(biao)面具有更(geng)高的(de)峰度(du)和(he)偏度,使表(biao)面(mian)有更多的“尖刺(ci)”,减少细菌(jun)黏附(fu)的(de)原(yuan)理与(yu)蝉翼(yi)的(de)杀菌作用(yong)相(xiang)似[45],通过细菌与(yu)材(cai)料(liao)的相(xiang)互作(zuo)用(yong)将其(qi)吸(xi)附(fu)在表(biao)面,导(dao)致(zhi)细菌的破(po)裂(lie)和(he)裂(lie)解。

CUNHA等学者[38]采(cai)用(yong)Yb:KYW激(ji)光器(qi)、发(fa)射(she)波长为1030nm、脉冲持(chi)续(xu)时间为(wei)500fs的激(ji)光,在钛(tai)合(he)金表面构(gou)建了(le)激(ji)光(guang)诱导周(zhou)期性表面(mian)纹(wen)理结构(gou)(LIPSS)和(he)纳米柱(zhu)2种表面(mian)织构(gou),其表面结构如(ru)图6所(suo)示(shi),其(qi)Ra值分(fen)别为(wei)0.3μm和(he)0.5μm,润湿(shi)角(jiao)分(fen)别为12.6°和(he)32.1°。对其(qi)进行(xing)细菌(jun)培(pei)养(yang)试(shi)验,未(wei)经激光处理(li)试(shi)样(yang)表面(mian)细菌(jun)覆(fu)盖(gai)率为(wei)25%,激光(guang)处(chu)理后试(shi)样(yang)表面(mian)金黄色葡萄球菌的覆(fu)盖(gai)率(lv)为(wei)7%,对(dui)于(yu)细菌的(de)生长(zhang)有较(jiao)好的抑制(zhi)作(zuo)用(yong)。研究(jiu)表(biao)明:金黄(huang)色(se)葡(pu)萄(tao)球菌优(you)先(xian)附着(zhe)于(yu)1~4nm的(de)钛(tai)合(he)金(jin)表面[46],在Ra为(wei)5~8μm的样(yang)品(pin)上形成的(de)生(sheng)物(wu)膜(mo)比在(zai)抛光(Ra=30nm)或机(ji)加工(Ra=0.5μm)表面(mian)上更(geng)强(qiang)烈[47]。细菌(jun)优先粘附在(zai)粗(cu)糙度(du)较(jiao)高(gao)的(de)表面,但也(ye)粘附(fu)在形(xing)貌(mao)特征(zheng)大于(yu)细菌(jun)尺(chi)寸(一般为1~2μm)的表(biao)面(mian)。因此(ci),激光(guang)诱导(dao)周(zhou)期(qi)性(xing)表面纹理(li)结构可(ke)以(yi)通过(guo)改(gai)善钛(tai)合(he)金表面(mian)的润(run)湿角(jiao)和粗(cu)糙度降低(di)细菌(jun)的黏(nian)附(fu)和(he)增殖(zhi)。

综上所述,激光(guang)表(biao)面(mian)处(chu)理后(hou)钛(tai)及钛(tai)合(he)金表面结构对(dui)于减少细(xi)菌(jun)的(de)黏附(fu)主(zhu)要包(bao)括(kuo)两(liang)方(fang)面:一是通(tong)过(guo)构(gou)建(jian)具有特征(zheng)尺(chi)寸(cun)小(xiao)于细(xi)菌尺寸和具有非常(chang)致(zhi)密的(de)特征表面(mian),减(jian)少细菌(jun)与(yu)表(biao)面的接触面积,抑(yi)制(zhi)细菌(jun)的(de)定(ding)植(zhi)或刺(ci)破细菌(jun),达到(dao)减少(shao)细菌(jun)滞留(liu)的目(mu)的;二(er)是通(tong)过增(zeng)大(da)表面的凹陷程(cheng)度(du),细(xi)菌无(wu)法(fa)穿过(guo)凹(ao)陷与(yu)表面建立稳定的连(lian)接,导致(zhi)细菌(jun)只(zhi)能黏(nian)附(fu)在(zai)个(ge)别的尖端(duan),防止生物膜的(de)形(xing)成(cheng)。
2.3 激(ji)光熔覆(fu)抗(kang)菌(jun)涂(tu)层(ceng)
激(ji)光(guang)熔(rong)覆技(ji)术可以在钛(tai)及(ji)钛(tai)合(he)金(jin)表面(mian)熔(rong)覆不(bu)同(tong)体系(xi)的(de)成分(fen),改善(shan)钛(tai)合金(jin)的性(xing)能。现(xian)阶(jie)段(duan),激(ji)光熔(rong)覆(fu)技(ji)术用于提(ti)高钛及(ji)钛(tai)合(he)金抗菌性能(neng)的(de)熔覆体(ti)系(xi)主要包括(kuo)生物(wu)医用金属(shu)材(cai)料(liao)(Ag,Cu,Nb,Zn,Ta等(deng)[48])、生(sheng)物陶瓷(HA,TiO2等(deng)[49])。激(ji)光(guang)熔(rong)覆技(ji)术(shu)可以(yi)显著(zhu)提高(gao)钛(tai)及钛(tai)合金(jin)的(de)抗(kang)菌(jun)性(xing)能,尤(you)其(qi)是对(dui)金(jin)黄色葡萄球(qiu)菌(jun)和(he)大肠(chang)杆菌等(deng)常(chang)见(jian)的致(zhi)病(bing)菌(jun)有较好的(de)抑(yi)制作(zuo)用(yong)[50]。
2.3.1 Ag抗菌涂(tu)层(ceng)
Ag具(ju)有超强的(de)抗菌(jun)性,被(bei)广泛应(ying)用于(yu)广谱杀(sha)菌材料。SHI等学(xue)者[51]通过(guo)对高(gao)真空电弧(hu)炉(lu)熔炼的(de)TiAg合(he)金进(jin)行抗菌(jun)性(xing)试(shi)验(yan),发现(xian):合金(jin)的(de)抗(kang)菌性(xing)是由于(yu)Ti2Ag和Ag+的共(gong)同(tong)作用(yong),且(qie)没(mei)有引起细(xi)胞(bao)毒性(xing)。CHEN等学者[52]制(zhi)成的Ti-Ag合(he)金在经过(guo)热(re)处理(li)后,对(dui)金黄(huang)色葡(pu)萄(tao)球(qiu)菌(jun)的抑(yi)制(zhi)率高(gao)达99%。表(biao)明:Ag的加(jia)入(ru)可(ke)以使合金获得(de)较强(qiang)且稳(wen)定(ding)的抗菌(jun)性能。
XUE等(deng)学(xue)者(zhe)[53]通过(guo)激(ji)光(guang)熔(rong)覆技(ji)术在Ti-20Zr10Nb-4Ta表面激光(guang)熔(rong)覆Ag箔,研(yan)究(jiu)Ag微(wei)粒(li)对于(yu)钛合(he)金(jin)抗(kang)菌(jun)性和相(xiang)容性(xing)的影(ying)响,试(shi)验(yan)结果(guo)表明(ming):当(dang)激光功(gong)率为50W和70W时(shi),经(jing)过(guo)处理(li)的(de)表(biao)面(mian)对于大(da)肠(chang)杆(gan)菌(jun)的(de)抑(yi)菌率(lv)分别达到(dao)96.3%和(he)98.2%,对(dui)于金(jin)黄色葡(pu)萄(tao)球菌(jun)的(de)抑(yi)菌(jun)率(lv)均(jun)达(da)到(dao)100%,且随着(zhe)激光功率(lv)的增(zeng)加(jia),表(biao)面形成(cheng)了钝化膜(mo),粗(cu)糙度(du)增大(da),具(ju)有(you)良(liang)好(hao)的耐(nai)腐(fu)蚀(shi)性(xing)能和生(sheng)物(wu)相(xiang)容(rong)性(xing)。ZHANG等学者[54]将Ag和ZnO纳(na)米(mi)颗粒(li)掺入(ru)羟基(ji)磷灰(hui)石(shi)纳(na)米(mi)粉体(ti)中,通过激光(guang)熔(rong)覆(fu)技术沉(chen)积(ji)在(zai)TC4表面(mian),对激光(guang)熔(rong)覆涂层的(de)抗菌性能和(he)骨(gu)整(zheng)合(he)性(xing)能进行(xing)研(yan)究(jiu)。研究(jiu)发(fa)现:纳(na)米Ag和(he)HA在(zai)熔(rong)覆(fu)层(ceng)表面呈(cheng)棒状,涂层与(yu)基(ji)体(ti)结(jie)合良好(hao),最大(da)熔(rong)深达到(dao)460μm,涂(tu)层的(de)最小(xiao)润湿角(jiao)约(yue)为10.5°。激(ji)光(guang)熔(rong)覆可(ke)以将(jiang)复合涂(tu)层(ceng)紧密(mi)地固定在TC4基(ji)体(ti)上(shang),抑制(zhi)了Ag离(li)子的(de)释(shi)放速率(lv),缓(huan)解了(le)高(gao)Ag浓度下(xia)的细(xi)胞毒性[55],涂层具有(you)优异的(de)细菌(jun)抗性(xing)、成(cheng)骨和(he)骨(gu)整合(he)能(neng)力(li)。MAHARUBIN等(deng)学者(zhe)[56]通(tong)过激(ji)光加(jia)工(gong)净(jing)成形(xing)工(gong)艺(yi)将(jiang)混(hun)合(he)均匀的cp-Ti粉和(he)Ag粉(fen)采用(yong)同步送粉方(fang)式在cp-Ti基体(ti)上制(zhi)备(bei)银(yin)含(han)量(质量(liang)分(fen)数(shu))为0.5%~2.0%的Ti-Ag合金,通过(guo)EDS检测发(fa)现:Ag均(jun)匀地分(fen)布(bu)在(zai)基体上(shang)。通过(guo)对不同Ag含(han)量(liang)的试(shi)样(yang)进(jin)行(xing)金(jin)黄(huang)色(se)葡萄(tao)球菌和(he)铜(tong)绿(lv)假(jia)单胞(bao)菌进(jin)行抗菌(jun)性(xing)试(shi)验,抗菌(jun)效果(guo)随(sui)Ag含量(liang)的增加(jia)而(er)增(zeng)强(qiang),当(dang)Ag含(han)量达(da)到1.5%时,抗菌(jun)率(lv)分别(bie)达到(dao)99.79%和99.96%,且在(zai)Ag含量(liang)较低时,可以(yi)在(zai)不(bu)损(sun)害生(sheng)物活(huo)性的(de)前提下(xia)最小化细(xi)菌感染的(de)风(feng)险(xian)。

目(mu)前,关(guan)于(yu)Ag对(dui)微(wei)生物的抑(yi)制和杀伤途(tu)径(jing)主要(yao)归(gui)结(jie)为以(yi)下(xia)观点(dian)[57],其抗(kang)菌原(yuan)理(li)如图7[58]所(suo)示。Ag能够(gou)抗菌的主要原(yuan)因是能被菌(jun)类(lei)吸附(fu),带(dai)正(zheng)电荷的Ag+能与(yu)带负电(dian)荷的微(wei)生(sheng)物之(zhi)间(jian)产(chan)生静(jing)电(dian)吸(xi)引(yin),从而促使Ag+附(fu)着(zhe)在细(xi)胞膜上(shang)[59],细(xi)菌(jun)的(de)细(xi)胞(bao)膜在(zai)与(yu)Ag接触几分(fen)钟(zhong)后(hou)就会被完全破(po)坏[60]。同时,Ag能够(gou)与(yu)细菌(jun)的蛋(dan)白质(zhi)相互结(jie)合,破(po)坏(huai)蛋白(bai)质(zhi)的(de)结(jie)构(gou),阻碍(ai)细菌的(de)新(xin)陈(chen)代(dai)谢(xie),从(cong)而失(shi)去活性(xing)[61]。Ag+浓度(du)的(de)提高(gao)会(hui)导(dao)致细胞(bao)氧(yang)化反应(ying)的增加(jia),微生(sheng)物(wu)细(xi)胞氧(yang)化应(ying)激(ji)的(de)增(zeng)加(jia)是(shi)Ag+引起毒性(xing)作用的标(biao)志。由(you)于Ag能(neng)够促进细(xi)胞(bao)产(chan)生ROS和自由基(ji),因此Ag具有(you)强大(da)的(de)抗菌(jun)、抗真菌和抗病毒(du)活性[62]。但是,抗菌性(xing)能与(yu)银(yin)含量不(bu)存在(zai)线(xian)性(xing)关系(xi),银(yin)含(han)量(liang)过高(gao)时,并不会显(xian)著(zhu)提高(gao)钛合金(jin)的(de)抗(kang)菌(jun)性(xing)能,反(fan)而可(ke)能(neng)产生(sheng)细(xi)胞毒性[63]。
2.3.2 Cu抗(kang)菌涂层
不(bu)同(tong)的(de)金(jin)属材料杀(sha)菌能力也有(you)所不同,其大(da)小(xiao)排(pai)序(xu)为:Cu>Fe>Sn>Al>Zn>Co[64]。Cu具有(you)促进成骨(gu)细胞(bao)分化,诱导(dao)血管(guan)生长的(de)作(zuo)用(yong)。同(tong)时(shi),作(zuo)为(wei)人(ren)体(ti)必需的(de)微量元(yuan)素,有(you)预(yu)防骨质疏(shu)松的作(zuo)用[65]。ZHANG等学者(zhe)[66]通过采用(yong)等离(li)子烧结(jie)技(ji)术制(zhi)备的Ti-Cu合(he)金对大(da)肠(chang)杆(gan)菌(jun)和金黄(huang)色葡(pu)萄(tao)球(qiu)菌的(de)抑制(zhi)率达到(dao)99%。有(you)研究(jiu)报(bao)道,只(zhi)有(you)Ti-Cu合(he)金(jin)的(de)Cu含(han)量(liang)(质量分(fen)数)在5%及以上(shang),合(he)金(jin)才(cai)具有(you)抗菌(jun)率(lv)>99%的(de)抗(kang)菌(jun)性(xing)能(neng)[67],表(biao)1为(wei)合(he)金(jin)中(zhong)Cu含量(liang)不(bu)同表(biao)现(xian)出的(de)抗菌(jun)性能[68-71]。

JI等学(xue)者(zhe)[72]采用激(ji)光选区(qu)熔化(hua)技(ji)术(shu)制(zhi)备(bei)的Ti-(3,5,7,10)Cu合金(质(zhi)量(liang)分(fen)数,%),Ti2Cu相在晶界(jie)预(yu)先形核并阻(zu)止晶(jing)粒长大,能够(gou)很好(hao)的起到(dao)细(xi)化(hua)晶粒(li)的作用。同(tong)时(shi),由于激(ji)光选区(qu)熔(rong)化快速凝固的特点,Ti的平(ping)均晶粒(li)尺(chi)寸为(wei)7.4μm,远(yuan)小(xiao)于(yu)常规(gui)铸造Ti的(de)晶(jing)粒(li)尺(chi)寸,快速凝(ning)固导(dao)致(zhi)表(biao)面(mian)收(shou)缩而(er)产生(sheng)的(de)细小孔(kong)洞(dong),增(zeng)加(jia)了细菌(jun)与合金(jin)的接触面积(ji),抗菌效(xiao)果(guo)明显(xian)增(zeng)加。合(he)金具有(you)较小(xiao)的(de)Cu2+释放且(qie)有较(jiao)高(gao)的(de)抗菌(jun)率(lv)。Ti-Cu合(he)金与(yu)细菌细胞(bao)膜(mo)的(de)直(zhi)接相互(hu)作用导致膜的渗透(tou)性(xing)增强,细(xi)菌允(yun)许(xu)Cu2+进(jin)入细(xi)胞内,引(yin)起接(jie)触杀(sha)菌(jun)[73]。经(jing)过激(ji)光选区(qu)熔化(hua)形(xing)成(cheng)的Ti-3Cu合金(jin)的(de)抗菌(jun)率相(xiang)对(dui)于相同成(cheng)分的铸(zhu)造(zao)合(he)金(jin),抗(kang)菌率(lv)提高约70%。
HOU等学者[74]通过激(ji)光熔(rong)覆(fu)技(ji)术(shu)在TC4表面(mian)原位制备(bei)掺(can)杂Cu颗粒的Ca-Si基涂层(ceng),研究表明(ming):激(ji)光(guang)处(chu)理(li)后(hou)原(yuan)位(wei)生(sheng)成(cheng)了Ca2SiO4,CaTiO3和(he)Cu2O,涂(tu)层表(biao)现(xian)出良(liang)好(hao)的耐(nai)磨(mo)性和润湿(shi)性;当(dang)Cu含量(liang)达到(dao)15%时,复合涂层(ceng)具有对大肠杆(gan)菌(jun)最(zui)高(gao)的抗菌活(huo)性。LIU等学者(zhe)[75]利用激光(guang)粉末(mo)床熔合(he)(LPBF)技(ji)术在纯钛基(ji)体(ti)上制(zhi)备(bei)抗(kang)菌(jun)Ti-Cu合(he)金(LPBF-TiCu),激光快速(su)加(jia)热和(he)冷却的(de)优点(dian)相对(dui)于(yu)传统方法制作的(de)Ti-Cu合(he)金(jin),会(hui)使(shi)Ti合(he)金形(xing)成(cheng)较(jiao)多的针(zhen)状马(ma)氏体(α′-Ti),由(you)于(yu)其具有(you)较低(di)的能(neng)量状态,会(hui)减缓(huan)钛合(he)金的(de)腐(fu)蚀(shi)[76]。Cu的(de)加入改善了(le)LPBF-TiCu合金中马(ma)氏体相(xiang)变时形(xing)状应变的(de)自适(shi)应(ying)性,减(jian)少(shao)了(le)位错在晶(jing)界(jie)的堆积(ji)。LPBFTiCu合(he)金(jin)可以(yi)显著(zhu)促进细(xi)胞(bao)的(de)增(zeng)殖(zhi),合金表面(mian)上的(de)细(xi)胞(bao)具(ju)有更(geng)多(duo)的(de)伪(wei)足,生(sheng)物相容(rong)性良好(hao),对金黄色葡萄(tao)球菌(jun)的(de)抑(yi)制率(lv)达(da)到94.81%,抗菌效果(guo)如(ru)图8所(suo)示(shi)。
目(mu)前(qian),关(guan)于(yu)激(ji)光熔(rong)覆(fu)含Cu涂(tu)层多用(yong)于(yu)改变金(jin)属的(de)耐磨性(xing)和耐腐(fu)蚀(shi)性[77−78],对(dui)于采用(yong)激(ji)光熔覆方式(shi)引入Cu提(ti)高植(zhi)入(ru)物(wu)抗菌性(xing)能(neng)的研究较(jiao)少。现阶段关于(yu)Cu2+的杀菌(jun)机理主要解释为含铜(tong)的抗菌金属材料在溶(rong)液或体(ti)液环(huan)境(jing)下(xia)溶(rong)出会(hui)释(shi)放带正(zheng)电(dian)的Cu2+离(li)子(zi),而细菌的(de)生物(wu)膜通(tong)常(chang)带(dai)负电荷,二者之间(jian)会产(chan)生(sheng)吸(xi)附(fu)作(zuo)用(yong),从而导(dao)致细(xi)胞膜(mo)上(shang)的(de)电(dian)荷分(fen)布(bu)不(bu)均匀,细菌形(xing)态在(zai)不均匀(yun)的库(ku)仑(lun)力作用下(xia)发(fa)生变(bian)形(xing),细(xi)胞膜的渗(shen)透性(xing)改(gai)变(bian),最终造(zao)成(cheng)细菌(jun)壁(bi)和(he)细菌膜的(de)破(po)裂,导(dao)致细胞(bao)质的溶(rong)出,从(cong)而(er)杀(sha)死细菌[79]。
3、结束语(yu)
(1)激光(guang)表(biao)面(mian)改性诱(you)导钛(tai)合(he)金(jin)产(chan)生抗菌(jun)涂(tu)层(ceng)的(de)调(diao)控机(ji)理(li)尚(shang)不(bu)明确,以(yi)及如(ru)何(he)提(ti)升(sheng)抗菌(jun)涂(tu)层制(zhi)造(zao)技术(shu)的(de)精确性,促进抗菌(jun)性(xing)和(he)生(sheng)物(wu)相(xiang)容性(xing)更加(jia)协调,是现(xian)阶段钛合金(jin)激(ji)光(guang)表面改性的(de)研(yan)究(jiu)重(zhong)点(dian)。
(2)虽(sui)然Ag,Cu等(deng)抗(kang)菌(jun)元素的(de)抗菌(jun)性(xing)已经(jing)得到(dao)验证。但是(shi),目前对(dui)于金(jin)属离(li)子的(de)抗(kang)菌机(ji)制及细胞毒(du)性机制(zhi)的(de)研究尚不(bu)明(ming)确。不论是(shi)通过构(gou)建含(han)有抗菌(jun)元素(su)的抗(kang)菌(jun)涂(tu)层(ceng)还(hai)是(shi)合金(jin)化(hua)处(chu)理(li),都(dou)需(xu)要(yao)保(bao)证(zheng)植入(ru)物的长期无(wu)害(hai)性。因(yin)此(ci),可以(yi)在(zai)保证抗(kang)菌元(yuan)素(su)的最(zui)小(xiao)添加量下,同时加(jia)入多(duo)种(zhong)微(wei)量(liang)抗(kang)菌元(yuan)素。
(3)对于(yu)钛(tai)及(ji)钛(tai)合(he)金的发(fa)展(zhan),仍然(ran)需(xu)要对(dui)引发(fa)炎(yan)症和(he)细菌感(gan)染(ran)方面(mian)投(tou)入(ru)大(da)量(liang)研(yan)究(jiu)。钛合(he)金的植入(ru)要在(zai)保证对(dui)人体组(zu)织长(zhang)期(qi)无(wu)害的前提下(xia),构建(jian)稳定(ding)且多功(gong)能(neng)的复合涂层(ceng)以(yi)满足(zu)实际(ji)应用(yong)中(zhong)的多(duo)种需求(qiu),是钛及钛(tai)合(he)金在(zai)生物医用领域(yu)中(zhong)未(wei)来研(yan)究的(de)主(zhu)要方(fang)向。
参考(kao)文(wen)献(xian)
[1]POU P, RIVEIRO A, DEL VAL J, et al. Laser surface texturing of titanium for bioengineering applications[J].Procedia Manufacturing, 2017, 13: 694 − 701.
[2]DU PLOOY R, AKINLABI E T. Analysis of laser cladding of titanium alloy[J]. Materials Today: Proceedings, 2018, 5(9): 19594 − 19603.
[3]孙(sun)壮, 王伟, 王成(cheng), 等(deng). 钛合(he)金表(biao)面激(ji)光(guang)熔(rong)覆耐(nai)磨和自(zi)润(run)滑(hua) 涂层(ceng)的(de)研究进(jin)展 [J]. 材(cai)料保护(hu), 2023, 56(1): 107 − 120.
SUN Zhuang, WANG Wei, WANG Cheng, et al. Research progress of wear-resistant and self-lubrication coatings prepared on titanium alloy surface by laser cladding[J]. Material Protection, 2023, 56(1): 107 − 120.
[4]LIU S Y, SHIN Y C. Additive manufacturing of Ti6Al4V alloy: A review[J]. Materials & Design, 2019, 164: 107552.
[5] 吴(wu)耀(yao)佳(jia), 张(zhang)懋达, 付永强, 等(deng). 含(han) Ag 硬质涂层的结构及(ji)其(qi) 摩(mo)擦(ca)腐(fu)蚀与(yu)抗菌特性的(de)研究(jiu)进展(zhan) [J]. 表(biao)面(mian)技(ji)术(shu), 2021, 50(1): 94 − 106, 161.
WU Yaojia, ZHANG Maoda, FU Yongqiang, et al. Research progress in structure, tribocorrosion and antibacterial properties of Ag-containing hard coatings[J]. Surface Technology, 2021, 50(1): 94 − 106, 161.
[6]APAZA-BEDOYA K, TARCE M, BENFATTI C A M, et al. Synergistic interactions between corrosion and wear at titanium-based dental implant connections: A scoping review[J]. Journal of Periodontal Research, 2017, 52(6): 946 − 954.
[7]CHAN C W, CARSON L, SMITH G C, et al. Enhancing the antibacterial performance of orthopaedic implant materials by fibre laser surface engineering[J]. Applied Surface Science, 2017, 404: 67 − 81.
[8]ZIMMERLI W. Clinical presentation and treatment of orthopaedic implant-associated infection[J]. Journal of Internal Medicine, 2014, 276(2): 111 − 119.
[9]CAMPOCCIA D, MONTANARO L, ARCIOLA C R. The significance of infection related to orthopedic devices and issues of antibiotic resistance[J]. Biomaterials, 2006, 27(11): 2331 − 2339.
[10]FLEMMING H C, VAN HULLEBUSCH E D, NEU T R. The biofilm matrix: multitasking in a shared space[J].Nature Reviews Microbiology, 2023, 21(2): 70 − 86.
[11]范(fan)竞(jing)一(yi), 马(ma)迅(xun), 李伟(wei), 等(deng). 医用(yong)钛(tai)合金表面改(gai)性技(ji)术研究进 展(zhan) [J]. 功(gong)能材(cai)料(liao), 2022, 53(7): 7027 − 7039.
FAN Jingyi, MA Xun, LI Wei, et al. Research progress of surface modification technology of biomedical titanium alloy[J]. Journal of Functional Materials, 2022, 53(7): 7027 − 7039.
[12]NIE Bin’en, LONG Teng, AO Haiyong, et al. Covalent immobilization of enoxacin onto titanium implant surfaces for inhibiting multiple bacterial species infection and in vivo methicillin-resistant staphylococcus aureus infection prophylaxis[J]. Antimicrobial Agents and Chemotherapy, 2016, 60(1): e01766 − 16.
[13]ALT V, BITSCHNAU A, ÖSTERLING J, et al. The effects of combined gentamicin-hydroxyapatite coating for cementless joint prostheses on the reduction of infection rates in a rabbit infection prophylaxis model[J].Biomaterials, 2006, 27: 4627 − 4634.
[14]DONG Yaning, LIU Li, SUN Jin, et al. Phosphonate/quaternary ammonium copolymers as high-efficiency antibacterial coating for metallic substrates[J]. Journal of Materials Chemistry B, 2021, 9(39): 8321 − 8329.
[15] 秦思民(min). 基于生物被(bei)膜的耐药性(xing)抗(kang)菌剂(ji)研(yan)究和(he)工(gong)程(cheng)新(xin)材(cai) 料(liao)探索 [D]. 北京(jing): 中国(guo)科(ke)学院(yuan)大(da)学, 2022.
QIN Simin. Research on drug-resistant antibacterial agents and exploration of new engineering materials based on biofilms[D]. Beijing, China: University of Chinese Academy of Sciences, 2022.
[16]王(wang)东生, 田(tian)宗(zong)军(jun), 沈理(li)达(da), 等. 激(ji)光(guang)熔(rong)覆(fu)技术(shu)研究(jiu)现(xian)状(zhuang)及(ji)其 发(fa)展(zhan) [J]. 应(ying)用(yong)激光(guang), 2012, 32(6): 538 − 544.
WANG Dongsheng, TIAN Zongjun, SHEN Lida, et al. Research status and development of laser cladding technology[J]. Applied Laser, 2012, 32(6): 538 − 544.
[17]崔振铎(duo), 朱家(jia)民(min), 姜(jiang)辉(hui), 等(deng). Ti 及(ji)钛合金(jin)表面(mian)改(gai)性(xing)在(zai)生(sheng)物(wu)医(yi) 用领(ling)域的(de)研(yan)究进展(zhan) [J]. 金(jin)属学报, 2022, 58(7): 837 − 856.
CUI Zhenduo, ZHU Jiamin, JIANG Hui, et al. Research progress of the surface modification of titanium and titanium alloys for biomedical application[J]. Acta Metallurgica Sinica, 2022, 58(7): 837 − 856.
[18]SIDDIQUI A A, DUBEY A K. Recent trends in laser cladding and surface alloying[J]. Optics & Laser Technology, 2021, 134: 106619.
[19]JU Jiang, ZAN Rui, SHEN Zhao, et al. Remarkable bioactivity, bio-tribological, antibacterial, and anti-corrosion properties in a Ti6Al4V-xCu alloy by laser powder bed fusion for superior biomedical implant applications[J].Chemical Engineering Journal, 2023, 471: 144656.
[20]张(zhang)永康, 周(zhou)建忠(zhong), 叶(ye)会霞, 等(deng). 激光(guang)加工技(ji)术 [M]. 北(bei)京: 化(hua) 学工业(ye)出版(ban)社(she), 2006.
ZHANG Yongkang, ZHOU Jianzhong, YE Huixia, et al. Laser processing technology [M]. Beijing, China: Chemical Industry Press, 2006.
[21]SYPNIEWSKA J, SZKODO M. Influence of laser modification on the surface character of biomaterials: Titanium and its alloys-A review[J]. Coatings, 2022, 12: 1371.
[22]LIU Zhifang, NIU Tong, LEI Yaxi, et al. Metal surface wettability modification by nanosecond laser surface texturing: A review[J]. Biosurface and Biotribology, 2022(2): 95 − 120.
[23]XU Yong, LIU Wei, ZHANG Gangqiang, et al. Friction stability and cellular behaviors on laser textured Ti6Al4V alloy implants with bioinspired micro-overlapping structures[J]. Journal of the Mechanical Behavior of Biomedical Materials, 2020, 109: 103823.
[24] WANG Xinlin, LEI Lei, YU Han. A review on microstructural features and mechanical properties of wheels/rails cladded by laser cladding[J]. Micromachines, 2021, 12(2): 152.
[25] ZHANG Yifu, ZHANG Hua, ZHU Zhengqiang, et al.Microstructure, properties and first principles calculation of titanium alloy/steel by Nd: YAG laser self-fluxing welding[J]. China Welding, 2018, 27(3): 1 − 10.
[26]周(zhou)佳(jia)良(liang), 舒凤(feng)远(yuan), 赵洪运, 等(deng). 激(ji)光熔覆在(zai) AlN 陶瓷表面(mian)制 备(bei)铜(tong)基金属(shu)覆(fu)层缺陷分(fen)析(xi)及(ji)控(kong)制 [J]. 焊(han)接(jie)学报(bao), 2019, 40(11): 133 − 138.
ZHOU Jialiang, SHU Fengyuan, ZHAO Hongyun, et al. Analysis and control of defects in preparing copper-based metal coatings on AlN ceramic surface by laser cladding[J].Transactions of the China Welding Institution, 2019, 40(11): 133 − 138.
[27]袁庆龙, 冯(feng)旭(xu)东(dong), 曹(cao)晶(jing)晶(jing), 等. 激光熔覆技(ji)术(shu)研(yan)究(jiu)进展 [J].材料(liao)导报(bao), 2010, 24(3): 112 − 116.
YUAN Qinglong, FENG Xudong, CAO Jingjing, et al. Research progress of laser cladding technology[J]. Materials Reports, 2010, 24(3): 112 − 116.
[28]王(wang)垚. 喷(pen)射(she)电沉积(ji)前(qian)处理(li)的激(ji)光(guang)表面(mian)处(chu)理(li)方(fang)法(fa)与试(shi)验研 究(jiu) [D]. 南京: 南(nan)京(jing)航空航天(tian)大(da)学, 2019.
WANG Yao. Experimental Study on Laser surface treatment method of pre-electrodeposition[D]. Nanjing, China: Nanjing University of Aeronautics and Astronautics, 2019.
[29]林基辉(hui), 刘(liu)德鑫, 李耀, 等. 激(ji)光合金化技术在表面(mian)改性中 的(de)应(ying)用研(yan)究(jiu)进(jin)展 [J]. 热加工(gong)工(gong)艺(yi), 2020, 49(8): 13 − 16.
LIN Jihui, LIU Dexin, LI Yao, et al. Research Progress in application of laser alloying technology in surface modification[J]. Hot Working Technology, 2020, 49(8): 13 − 16.
[30]QIAO Q, CRISTINO V A M, TAM L M, et al. Characterization of laser surface-alloyed Ti-Ni-Ag coatings and evaluation of their corrosion and antibacterial performance[J]. Surface and Coatings Technology, 2023, 474: 130119.
[31]CHAN C W, LEE S, SMITH G, et al. Enhancement of wear and corrosion resistance of beta titanium alloy by laser gas alloying with nitrogen[J]. Applied Surface Science, 2016, 367: 80 − 90.
[32]SANTOS E C, MORITA M, SHIOMI M, et al. Laser gas nitriding of pure titanium using CW and pulsed Nd: YAG lasers[J]. Surface and Coatings Technology, 2006, 201: 1635 − 1642.
[33]邹洁, 陈洁(jie), 胡滨. TiN 涂(tu)层(ceng)对牙(ya)科钴(gu)铬(ge)合(he)金抗(kang)菌腐(fu)蚀性能(neng) 的影响 [J]. 上海口(kou)腔医学(xue), 2010, 19(2): 173 − 177.
ZOU Jie, CHEN Jie, HU Bin. Effect of titanium nitride coating on bacterial corrosion resistance of dental Co-Cr alloy[J]. Shanghai Journal of Stomatology, 2010, 19(2): 173 − 177.
[34] DONAGHY C L, MCFADDEN R, KELAINI S, et al. Creating an antibacterial surface on beta TNZT alloys for hip implant applications by laser nitriding[J]. Optics & Laser Technology, 2020, 121: 105793.
[35]肖(xiao)忆楠(nan), 乔岩欣, 李(li)月(yue)明(ming), 等(deng). 医用(yong)钛(tai)及(ji)钛(tai)合(he)金表(biao)面改(gai)性技(ji) 术的(de)研究(jiu)进展 [J]. 材料导(dao)报, 2019, 33(Z2): 336 − 342.
XIAO Yinan, QIAO Yanxin, LI Yueming, et al. Research development of surface modification technology of biomedical titanium and titanium alloy[J]. Materials Reports, 2019, 33(Z2): 336 − 342.
[36]FATHI-HAFSHEJANI P, JOHNSON H, AHMADI Z, et al. Phase-selective and localized TiO2 coating on additive and wrought titanium by a direct laser surface modification approach[J]. ACS Omega, 2020, 5(27): 16744 − 16751.
[37]PARMAR V, KUMAR A, SANKAR M M, et al. Oxidation facilitated antimicrobial ability of laser micro-textured titanium alloy against gram-positive Staphylococcus aureus for biomedical applications[J]. Journal of Laser Applications, 2018, 30(3): 032001.
[38]
CUNHA A, ELIE A M, PLAWINSKI L, et al. Femtosecond laser surface texturing of titanium as a method to reduce the adhesion of Staphylococcus aureus and biofilm formation[J]. Applied Surface Science, 2016, 360: 485 − 493.
[39]VARIOLA F, YI J H, RICHERT L, et al. Tailoring the surface properties of Ti6Al4V by controlled chemical oxidation[J]. Biomater, 2008, 29(10): 1285 − 1298.
[40]李(li)华(hua)晨(chen), 周广(guang)涛(tao), 陈(chen)梅峰(feng), 等. 分步(bu)气(qi)体(ti)介(jie)质(zhi)下低(di)功率激光(guang) 焊接薄(bao)板(ban)紫铜成形(xing)及组织和性(xing)能(neng) [J]. 焊(han)接(jie)学报(bao), 2020, 41(10): 65 − 72.
LI Huachen, ZHOU Guangtao, CHEN Meifeng, et al. Research on laser welding formability and microstructure property of copper in stepwise gas medium[J]. Transactions of the China Welding Institution, 2020, 41(10): 65 − 72.
[41]GALLARDO-MORENO A M, PACHA-OLIVENZA M A, SALDAÑA L, et al. In vitro biocompatibility and bacterial adhesion of physico-chemically modified Ti6Al4V surface by means of UV irradiation[J]. Acta Biomaterialia, 2009, 5(1): 181 − 192.
[42]MITIK-DINEVA N, WANG J, TRUONG V K, et al. Escherichia coli, Pseudomonas aeruginosa, and Staphylococcus aureus attachment patterns on glass surfaces with nanoscale roughness[J]. Current Microbiology, 2009, 58: 268 − 273.
[43] JEYACHANDRAN Y L, NARAYANDASS S K. The effect of thickness of titanium nitride coatings on bacterial adhesion[J]. Trends in Biomaterials and Artificial Organs, 2010, 24(2): 90 − 93.
[44] GIRALDEZ M J, RESUA C G, LIRA M, et al. ContactLens hydrophobicity and roughness effects on bacterial adhesion[J]. Optometry and Vision Science, 2010, 87(6): E426 − E431.
[45]POGODIN S, HASAN J, BAULIN V A, et al. Biophysical model of bacterial cell interactions with nanopatterned cicada wing surfaces[J]. Biophysical Journal, 2013, 104(4): 835 − 840.
[46]TRUONG V K, LAPOVOK R, ESTRIN Y S, et al. The influence of nano-scale surface roughness on bacterial adhesion to ultrafine-grained titanium[J]. Biomaterials, 2010, 31(13): 3674 − 3683.
[47]BRAEM A, VAN MELLAERT L, MATTHEYS T, et al. Staphylococcal biofilm growth on smooth and porous titanium coatings for biomedical applications[J]. Journal of Biomedical Materials Research Part A, 2014, 102: 215 − 224.
[48]司银(yin)芳, 胡(hu)语婕(jie), 张凡, 等. 生物合成(cheng)氧(yang)化锌(xin)纳米(mi)颗粒(li)材料 及其(qi)抗(kang)菌(jun)应用(yong) [J]. 化工(gong)进(jin)展(zhan), 2023, 42(4): 2013 − 2023.
SI Yinfang, HU Yujie, ZHANG Fan, et al. Biosynthesis of zinc oxide nanoparticles and its application to antibacterial[J]. Chemical Industry and Engineering Progress, 2023, 42(4): 2013 − 2023.
[49]许晴. 生(sheng)物活(huo)性(xing)陶(tao)瓷(ci)复合材(cai)料制备(bei)及(ji)其抗(kang)菌和再(zai)生修(xiu)复(fu) 研(yan)究(jiu) [D]. 北京(jing): 中(zhong)国(guo)科(ke)学(xue)院大(da)学(xue), 2021.
XU Qing. Preparation of bioactive ceramic composites and its antibacterial activity and regenerative repair effect[D]. Beijing, China: University of Chinese Academy of Sciences, 2021.
[50]ZHOU Yazhou, YANG Juan, HE Tingting, et al. Highly stable and dispersive silver nanoparticle-graphene composites by a simple and low-energy-consuming approach and their antimicrobial activity[J]. Small, 2013, 9(20): 3445 − 3454.
[51]SHI Anqi, ZHU Chenshun, FU Shan, et al. What controls the antibacterial activity of Ti-Ag alloy, Ag ion or Ti2Ag particles?[J]. Materials Science and Engineering: C, 2020, 109: 110548.
[52]CHEN Mian, YANG Lei, ZHANG Lan, et al. Effect of nano/micro-Ag compound particles on the bio-corrosion, antibacterial properties and cell biocompatibility of Ti-Ag alloys[J]. Materials Science and Engineering: C, 2017, 75: 906 − 917.
[53]XUE Xianda, LU Libin, HE Donglei, et al. Antibacterial properties and cytocompatibility of Ti-20Zr-10Nb-4Ta alloy surface with Ag microparticles by laser treatment[J]. Surface and Coatings Technology, 2021, 425: 27716.
[54] ZHANG Yanzhe, LIU Xiangmei, LI Zhaoyang, et al. Nano Ag/ZnO-incorporated hydroxyapatite composite coatings: highly effective infection prevention and excellent osteointegration[J]. ACS Applied Materials & Interfaces, 2018, 10(1): 1266 − 1277.
[55]丁婷婷(ting). 含(han)银纳米(mi)材(cai)料(liao)的(de)制备(bei)、抗菌性能(neng)及(ji)细(xi)胞(bao)毒性研 究 [D]. 长(zhang)沙: 湖南大学(xue), 2020.
DING Tingting. Preparation, antibacterial properties and cytotoxicity of silver-containing nanomaterials[D]. Changsha, China: Hunan University, 2020.
[56]MAHARUBIN S, HU Y B, SOORIYAARACHCHI D. Laser engineered net shaping of antimicrobial and biocompatible titanium-silver alloys[J]. Materials Science and Engineering: C, 2019, 105: 110059.
[57]李(li)波. 基于银基纳米(mi)复合(he)生物(wu)材(cai)料(liao)靶向协(xie)同抗(kang)菌用(yong)于(yu)骨(gu) 感染治(zhi)疗(liao) [D]. 上海(hai): 东(dong)华大学, 2022.
LI Bo. Targeted synergistic antibacterial based on silverbased nanocomposite biomaterials for bone infection treatment[D]. Shanghai, China: Donghua University, 2022.
[58]SHI Pengyan, SUN Haoliang, ZHANG Haoge, et al. Highly effective antibacterial properties of self-formed Ag nanoparticles/Zr-Ag granular films[J]. Applied Surface Science, 2023, 622: 156929.
[59]ABBASZADEGAN A, GHAHRAMANI Y, GHOLAMI A, et al. The effect of charge at the surface of silver nanoparticles on antimicrobial activity against gram-positive and gram-negative bacteria: A preliminary study[J]. Journal of Nanomaterials, 2015, 2015: 720654.
[60]RAFFI M, HUSSAIN F, BHATTI T M, et al. Antibacterial characterization of silver nanoparticles against E. coli ATCC15224[J]. Journal of Materials Science & Technology, 2008, 24(2): 192 − 196.
[61]张俊敏. Ti-Ta-Ag 合金(jin)的放电(dian)等离(li)子(zi)体烧(shao)结(jie)合(he)成(cheng)机(ji)理及 其性(xing)能(neng)研究 [D]. 昆(kun)明(ming): 昆(kun)明(ming)理工(gong)大(da)学(xue), 2022.
ZHANG Junmin. Study on the synthesis mechanism and properties of Ti-Ta-Ag alloy by spark plasma sintering[D]. Kunming, China: Kunming University of Science and Technology, 2022.
[62]KIM S, LEE H S, RYU D, et al. Antibacterial activity of silver-nanoparticles against Staphylococcus aureus and Escherichia coli[J]. Korean Journal of Microbiology & Biotechnology, 2011, 39(1): 77 − 85.
[63]FENG Q L, WU J, CHEN G Q, et al. A mechanistic study of the antibacterial effect of silver ions on Escherichia coli and Staphylococcus aureus[J]. Journal of Biomedical Materials Research, 2000, 52(4): 662 − 668.
[64]
罗(luo)娟(juan). 纳(na)米 Ag-Cu 基抗(kang)菌材(cai)料的(de)制(zhi)备(bei)及(ji)其(qi)性(xing)能研(yan)究(jiu) [D].昆明: 昆明理工(gong)大(da)学(xue), 2022.
LUO Juan. Preparation and properties of nano Ag-Cu based antibacterial materials[D]. Kunming, China: Kunming University of Science and Technology, 2022.
[65]SRIKANT P, REDDY C K, RAM N R. Metallic particulates for preparation of anti-bacterial preservation vassals and their applications-A review[J]. Materials Today: Proceedings, 2019, 18: 440 − 444.
[66]ZHANG Erlin, FU Shan, WANG Ruoxian, et al. Role of Cu element in biomedical metal alloy design[J]. Rare Metals, 2019, 38(6): 476 − 494.
[67]ZHANG Erlin, LI Shengyi, REN Jing, et al. Effect of extrusion processing on the microstructure, mechanical properties, biocorrosion properties and antibacterial properties of Ti-Cu sintered alloys[J]. Materials Science and Engineering: C, 2016, 69: 760 − 768.
[68]LIU Jie, LI Fangbing, LIU Cong, et al. Effect of Cu content on the antibacterial activity of titanium-copper sintered alloys[J]. Materials Science and Engineering: C, 2014, 35: 392 − 400.
[69]FOWLER L, JANSON O, ENGQVIST H, et al. Antibacterial investigation of titanium-copper alloys using luminescent Staphylococcus epidermidis in a direct contact test[J].Materials Science and Engineering: C, 2019, 97: 707 − 714.
[70]BAO Mianmian, LIU Ying, WANG Xiaoyan, et al. Optimization of mechanical properties, biocorrosion properties and antibacterial properties of wrought Ti-3Cu alloy by heat treatment[J]. Bioactive Materials, 2018, 3(1): 28 − 38.
[71]ZHANG Erlin, REN Jing, LI Shengyi, et al. Optimization of mechanical properties, biocorrosion properties and antibacterial properties of as-cast Ti-Cu alloys[J].Biomedical Materials, 2016, 11: 065001.
[72]JI Hairui, ZHAO Mingchun, XIE Bin, et al. Corrosion and antibacterial performance of novel selective-laser-melted (SLMed) Ti-xCu biomedical alloys[J]. Journal of Alloys and Compounds, 2021, 8644: 158415.
[73]PENG Cong, ZHANG Shuyuan, SUN Ziqing, et al. Effect of annealing temperature on mechanical and antibacterial properties of Cu-bearing titanium alloy and its preliminary study of antibacterial mechanism[J]. Materials Science andEngineering: C, 2018, 93: 495 − 504.
[74]HOU Baoping, YANG Zhao, YANG Yuling, et al. In vitro bioactivity, tribological property, and antibacterial ability of Ca-Si-based coatings doped with cu particles in-situ fabricated by laser cladding[J]. Applied Physics A, 2018, 124: 256.
[75]LIU Hui, SHI Lizhen, LIU Huan, et al. Corrosion behavior of laser powder bed fusion prepared antibacterial Cu-bearing titanium alloy[J]. Materials Letters, 2023, 331: 133496.
[76]KASCHEL F R, KEAVENEY S, DOWLING D P. Comparison between continuous and modulated wave laser emission modes for the selective laser melting of Ti-6Al-4V: Dimensional accuracy, microstructure and mechanical behaviour[J]. Additive Manufacturing, 2022, 55: 102825.
[77]谢发(fa)勤(qin), 何鹏(peng), 吴(wu)向(xiang)清, 等. 钛(tai)合(he)金(jin)表面激(ji)光熔覆(fu)技术(shu)的(de)研(yan) 究(jiu)及(ji)展望(wang) [J]. 稀有金(jin)属材(cai)料(liao)与工(gong)程, 2022, 51(4): 1514 − 1524.
XIE Fanqin, HE Peng, WU Xiangqing, et al. Research and prospect of laser cladding technology on titanium alloy surface[J]. Rare Metal Materials and Engineering, 2022, 51(4): 1514 − 1524.
[78]黄(huang)湘(xiang)湘(xiang). 碳(tan)钢表(biao)面激(ji)光(guang)熔覆铝青铜合(he)金组织(zhi)和性(xing)能(neng)研(yan)究[D]. 上海: 上海(hai)交(jiao)通(tong)大(da)学, 2019.
HUANG Xiangxiang. Microstructure and properties of laser cladded aluminum bronze coating on carbon steel[D]. Shanghai, China: Shanghai Jiao Tong University, 2019.
[79]王(wang)亚(ya)迪(di). 基于(yu)阳离(li)子(zi)-π 作用的(de)铜(tong)复合(he)物的抗菌性能与机(ji) 理研(yan)究(jiu) [D]. 北京: 中(zhong)国(guo)科(ke)学院(yuan)大学, 2020. WANG Yadi. Copper complexes based on cation-π interaction: Preparation characterization and antimicrobial activities[D]. Beijing, China: University of Chinese Academy of Sciences, 2020.
第(di)一作(zuo)者(zhe): 马振,博(bo)士,副(fu)教授;主(zhu)要从(cong)事(shi)医(yi)用钛(tai)合(he)金(jin)表面 改性的(de)科研(yan)和(he)教(jiao)学(xue)工(gong)作(zuo);已(yi)发表(biao)论(lun)文(wen) 20 余篇;jmsdxmz@http://www.gzhwkf.com。通信作(zuo)者(zhe): 牟立婷,博士,副(fu)教(jiao)授;主要从事医(yi)用(yong)生物(wu)材料 研(yan)究(jiu);muliting@http://www.gzhwkf.com。
相(xiang)关链接